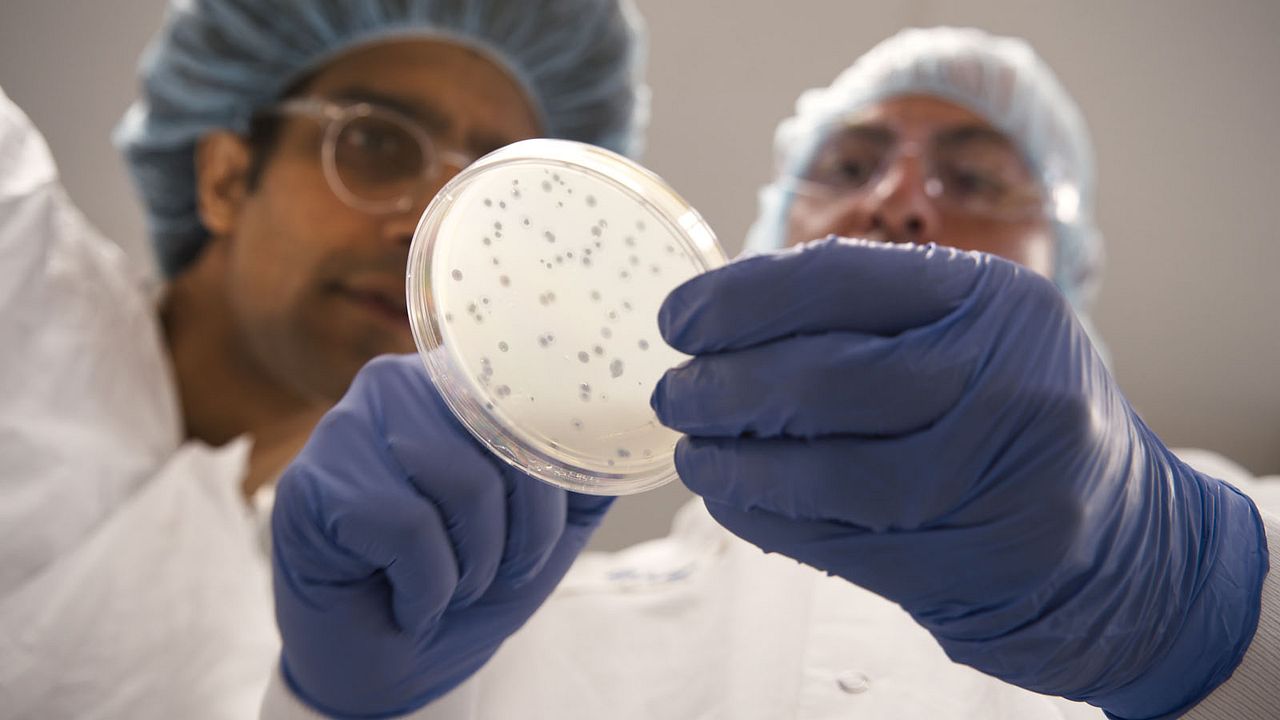
Superconectados : Foto

2 / 7 Fotos
Superconectados : Foto